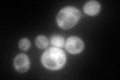
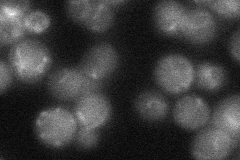
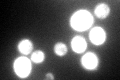
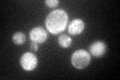

View description
NAD-dependent glycerol 3-phosphate dehydrogenase, homolog of Gpd1p, expression is controlled by an oxygen-independent signaling pathway required to regulate metabolism under anoxic conditions; located in cytosol and mitochondria
Localization:
Intensity:
Fold change:
Significance:
-
C’ GFP library in SD
cytosol164.67 -
N' NOP1pr-GFP in SD

mitochondria129.779 -
N' TEF2pr-mCherry in SD

mitochondria173.541 -
N' NATIVEpr-GFP in SD
mitochondria23.2051 -
N' TEF2pr-VC and Cyto-VN in SD

#N/A0 -
C’ GFP library in SD+DTT
cytosol143.850.87No -
C’ GFP library in SD+H2O2

cytosol220.811.34No -
C’ GFP library in Starvation Media
cytosol122.630.74No -
C’ GFP library on the background of Pup2-DaMP

cytosol -
C’ GFP library on the background of CCT mutant

cytosol150.0940.911453No
